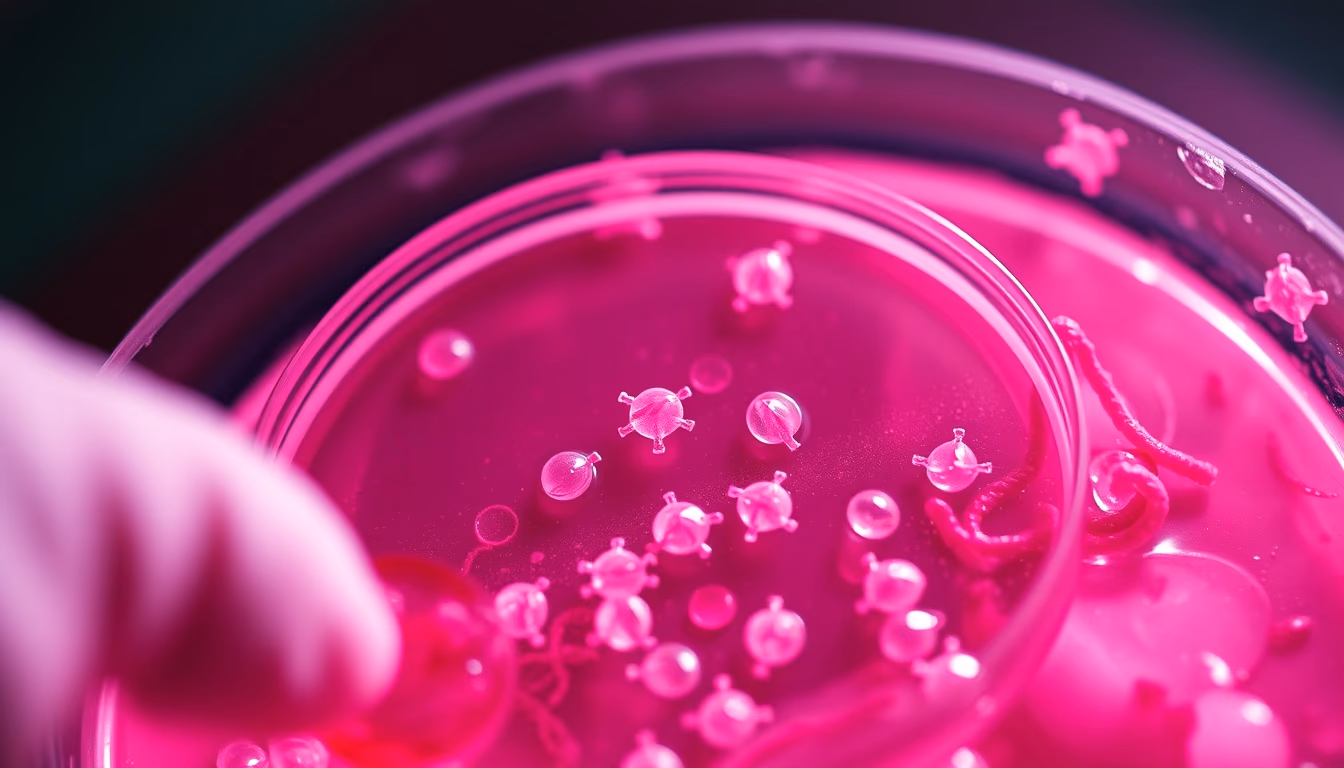
stem cells petri dish in editorial style

Brazilian image library, free with attribution
High-quality stock photos about Brazil. AI-curated for editorial use, business, blogs and presentations.

Tissue culture biology lab
biology1344×768
Stem cells petri dish
biology1344×768
Mrna vaccine vial closeup
biology1344×768
Crispr gene editing concept
biology1344×768
Gene therapy concept render
biology1344×768
Enzyme catalysis 3d
biology1344×768
Antibody structure render
biology1344×768
Plant cell wall closeup
biology1344×768
Red blood cells flowing
biology1344×768
White blood cells macro
biology1344×768
Dna helix glowing blue
biology1344×768
Ribosome detail render
biology1344×768
Mitochondria 3d render
biology1344×768
Nucleus chromosomes microscope
biology1344×768
Protein structure 3d
biology1344×768
Virus 3d render covid
biology1344×768
Bacterial colony petri dish
biology1344×768
Rna molecule structure
biology1344×768
Cell division microscope
biology1344×768
Birth of venus botticelli
biology1344×768
Cello in concert hall
biology1344×768
Clinical trial vials
biology1344×768
Pharmaceutical research lab
biology1344×768
Biomedical lab clean
biology1344×768
Electron microscope sample
biology1344×768
Pcr machine running cycle
biology1344×768
Gene therapy concept render
biology1344×768
Cell sorting facs machine
biology1344×768
Mrna vaccine vial closeup
biology1344×768
Tissue culture biology lab
biology1344×768
Stem cells petri dish
biology1344×768
Antibody structure render
biology1344×768
Crispr gene editing concept
biology1344×768
Enzyme catalysis 3d
biology1344×768
Plant cell wall closeup
biology1344×768
White blood cells macro
biology1344×768
Virus 3d render covid
biology1344×768
Red blood cells flowing
biology1344×768
Nucleus chromosomes microscope
biology1344×768
Ribosome detail render
biology1344×768
Bacterial colony petri dish
biology1344×768
Protein structure 3d
biology1344×768
Rna molecule structure
biology1344×768
Dna helix glowing blue
biology1344×768
Mitochondria 3d render
biology1344×768
Cell division microscope
biology1344×768
Popular tags
- global 979
- unique-2500 559
- trending-2026 263
- anomaly-detected 159
- travel 146
- magazine-editorial 122
- commercial-product-photography 97
- fine-art-photography 89
- minimalist-composition 83
- nature 75
- aerial-drone-shot 73
- cinematic-wide-shot 71
- macro-closeup 68
- lifestyle 66
- documentary-photography 61
- food 57
- cripto 54
- business 49
- infrastructure 45
- studio-editorial-portrait 43
License: free with attribution
All images are licensed under Creative Commons Attribution 4.0 (CC-BY 4.0). You can use them in commercial and non-commercial projects, just credit "UtilizAí" with a link back to xn--utiliza-eza.com.